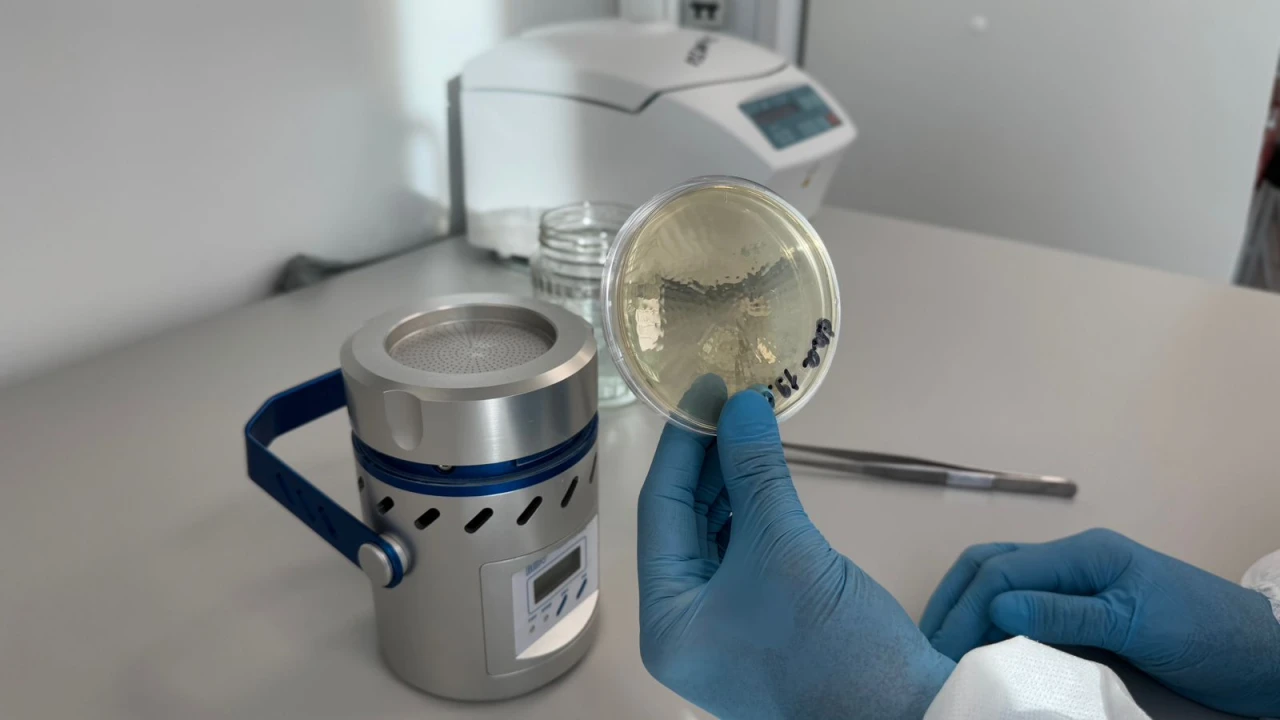
Ауаның санитариялық-микробиологиялық көрсеткіштері: маңызы және бақылау жүйесі
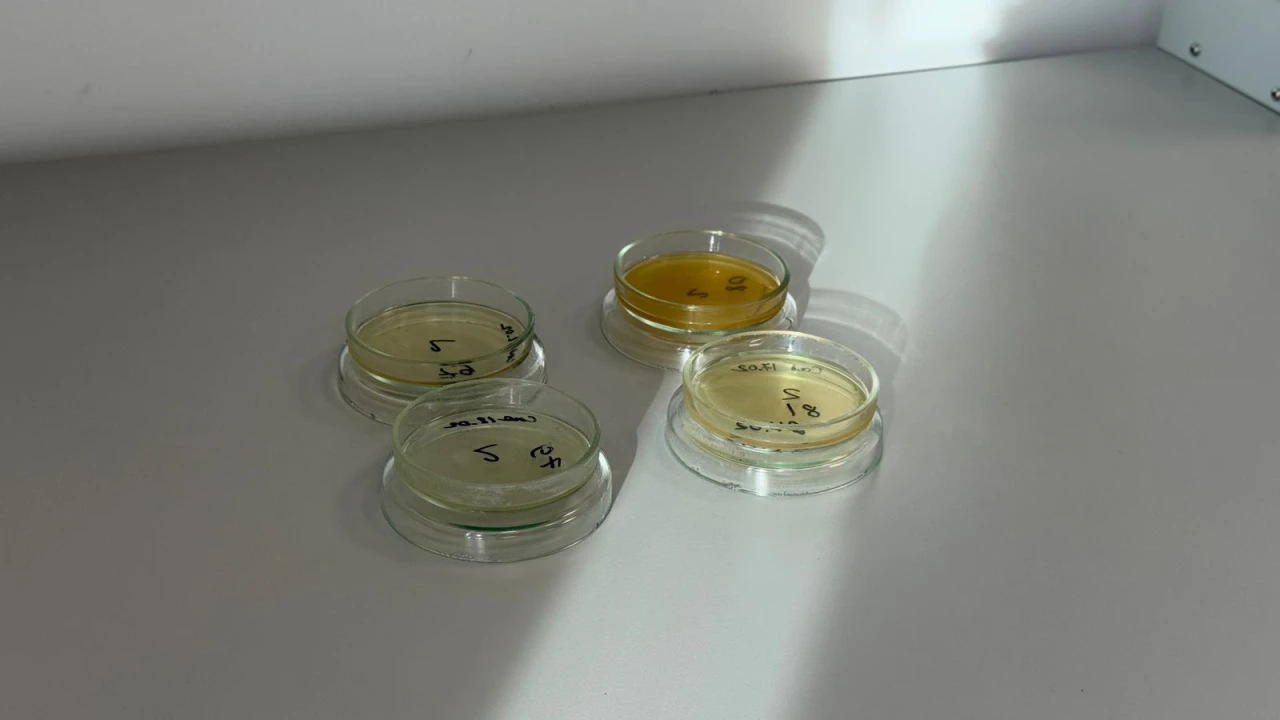
Ауаның санитариялық-микробиологиялық көрсеткіштері: маңызы және бақылау жүйесі

Өндірістік және қоғамдық ғимараттардағы ауа – санитариялық-эпидемиологиялық саулықты айқындайтын маңызды факторлардың бірі. Ауа ортасы өнімдерді, әртүрлі беткейлерді, жабдықтарды және биологиялық нысандарды ластайтын микроорганизмдердің таралу көзі болуы мүмкін. Осыған байланысты ауаның санитариялық-микробиологиялық бақылауы өндірістік және эпидемиологиялық қадағалау жүйесінің ажырамас құрамдас бөлігі болып табылады.
Ауаның негізгі санитариялық-микробиологиялық көрсеткіштері
Ауа ортасының микробтық ластану деңгейін сипаттайтын негізгі көрсеткіштерге мыналар жатады:
• микроорганизмдердің жалпы саны (ЖМС, КТБ/м³);
• зең және ашытқы саңырауқұлақтары;
• санитариялық-көрсеткіштік микроорганизмдер;
• шартты-патогенді және патогенді бактериялар (қауіп деңгейі жоғары нысандарда).
Аталған көрсеткіштер ғимараттың санитариялық жағдайын, желдету жүйесінің тиімділігін, тазалау жұмыстарының сапасын және персоналдың гигиеналық талаптарды сақтау деңгейін кешенді түрде бағалауға мүмкіндік береді.
Санитариялық бақылау жүргізілетін нысандар
Ауаның микробиологиялық мониторингі келесі объектілерде жүзеге асырылады:
• микробиологиялық және клиникалық зертханаларда;
• медициналық ұйымдарда;
• тағам және фармацевтикалық өндіріс орындарында;
• дәріханалар мен косметикалық өндіріс цехтарында;
• балалар және өзге де қоғамдық мекемелерде;
• дайын өнімдер мен шикізат сақталатын қойма үй-жайларында.
Зерттеу әдістері
Іс жүзінде ауаны зерттеудің екі негізгі әдісі кеңінен қолданылады:
Седиментациялық (шөктіру) әдіс – микроорганизмдердің ашық Петри табақшаларындағы қоректік орта бетіне табиғи жолмен шөгуіне негізделген. Бұл әдіс қарапайым әрі қолжетімді болғандықтан, көбіне бағдарлық бағалау үшін пайдаланылады.
Аспирациялық (көлемдік) әдіс – ауа арнайы аспиратор құрылғысы арқылы өткізіліп, микроорганизмдер қоректік ортаға тұндырылады. Нәтижесінде КТБ/м³ көрсеткіші сандық түрде анықталады. Бұл әдіс жоғары дәлдігімен ерекшеленеді және сенімді нәтижелер алуға мүмкіндік береді.
Ауаның микробтық ластануына әсер ететін факторлар
Ауадағы микробтық жүктеменің артуы келесі жағдайларда байқалады:
• адамдардың шамадан тыс шоғырлануы;
• шаңдану және ылғалдылық деңгейінің жоғары болуы;
• желдету жүйесінің тиімсіздігі;
• тазалау және дезинфекциялау режимдерінің сақталмауы;
• ғимараттардың санитариялық жағдайының талапқа сай болмауы.
Ауаны бақылаудың санитариялық маңызы
Ауа ортасын жүйелі микробиологиялық бақылау:
• нысандардың санитариялық жағдайын объективті бағалауға;
• микробтық ластану көздерін дер кезінде анықтауға;
• желдету мен тазалау жұмыстарының тиімділігін қадағалауға;
• өнімнің микробтық контаминациясының алдын алуға;
• инфекциялық аурулардың таралу қаупін және өндірістік ақауларды төмендетуге мүмкіндік береді.
Қорытындылай келе, ауаның санитариялық-микробиологиялық көрсеткіштері – қоршаған ортаның гигиеналық қауіпсіздігін және өндірістік үдерістердің сапасын айқындайтын маңызды өлшем. Ауа ортасына тұрақты мониторинг жүргізу – эпидемиологиялық және өндірістік қауіпсіздікті қамтамасыз етудің міндетті шарты.



